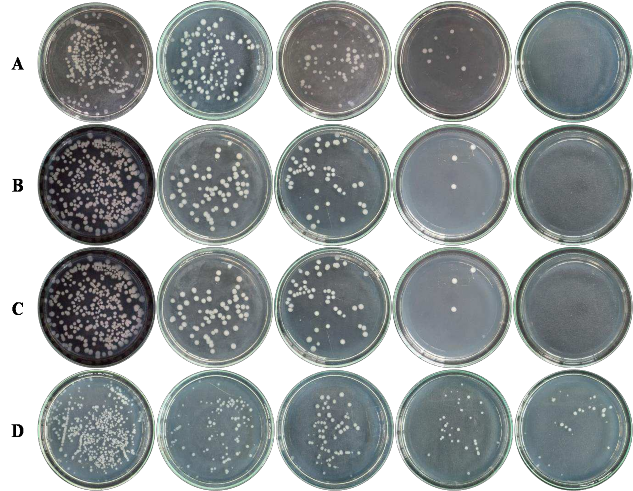
0 phút 30 phút 60 phút 90 phút 120 phút Hình 3 14 Khuẩn lạc của các chủng vi khuẩn 1
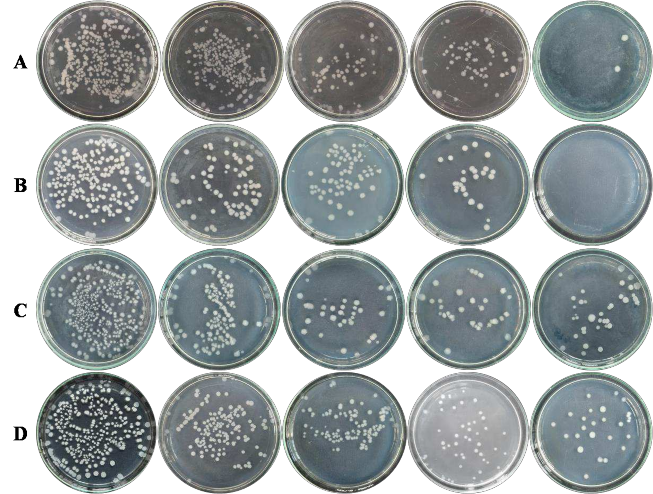
0 phút 30 phút 60 phút 90 phút 120 phút Hình 3 15 Khuẩn lạc của các chủng vi khuẩn 2

Với mức thời gian 60 phút, mật độ bào tử cao nhất ở chủng VBt2762.1 (2,7 x 106 CFU/mL) và thấp nhất ở chủng VBt2119.1 (0,0 CFU/mL). Ở 90 phút, có 4 chủng vi khuẩn không có khả năng chống chịu tia UV. Ở 120 phút, chỉ còn 3 chủng VBt21110.1 (5,4 x 103 CFU/mL), VBt26310.1 (2,8 x 102 CFU/mL) và VBt2751
(4,0 x 103 CFU/mL) tồn tại. Khi tăng thời gian chiếu tia UV lên 150 phút, thì tất cả các chủng vi khuẩn đều chết (Bảng 3.15).
Bảng 3.15 Mật độ bào tử (CFU/mL) của 12 chủng vi khuẩn B. thuringiensis var.
kurstaki sau khi chiếu UV ở bước sóng 254 nm
Chủng vi
Mật độ bào tử (CFU/mL)
0 phút | 30 phút | 60 phút | 90 phút | 120 phút | |
VBt2119.1 | 2,0 x 108 | 3,0 x 102 a | 0,0 a | 0,0 a | 0,0 a |
VBt21110.1 | 2,0 x 108 | 7,0 x 106 c | 1,4 x 106 c | 1,3 x 105 c | 5,4 x 103 c |
VBt26310.1 | 2,0 x 108 | 6,9 x 106c | 1,7 x 104 b | 7,5x 103 bc | 2,8 x 102 b |
VBt26311.1 | 2,0 x 108 | 2,4 x 106 c | 4,6 x 103 b | 1,1 x 103 b | 0,0 a |
VBt26317.3 | 2,0 x 108 | 4,0 x 106c | 3,5 x 106 c | 2,1 x 104 c | 0,0 a |
VBt2813 | 2,0 x108 | 5,4 x 106 c | 2,7 x 104 b | 1,2 x 103 b | 0,0 a |
VBt2735.1 | 2,0 x108 | 2,3 x 105 b | 6,8 x 102 a | 0,0a | 0,0 a |
VBt2736.2 | 2,0 x 108 | 3,0 x 106 c | 6,3 x 104 b | 0,0 a | 0,0 a |
VBt2751 | 2,0 x 108 | 4,7 x 106 c | 1,1 x 106 c | 1,3 x 105 c | 4,0 x 103 c |
VBt27510 | 2,0 x 108 | 4,5 x 106 c | 2,1 x 106 c | 3,4 x 104 c | 0,0 a |
VBt2762.1 | 2,0 x108 | 6,0 x 106 c | 2,6 x 104 b | 0,0 a | 0,0 a |
VBt2767.6 | 2,0 x 108 | 3,0 x 106 c | 2,7 x 106 c | 3,7 x 103 bc | 0,0 a |
Mức ý nghĩa | ns | ** | ** | ** | ** |
CV (%) | - | 15,6 | 11,0 | 12,6 | 4,7 |
Có thể bạn quan tâm!
-
Xác Định Sự Hiện Diện Gen Cry Của Vi Khuẩn B. Thuringiensis Var. Kurstaki -
Phân Nhóm Quan Hệ Của Trình Tự Các Mẫu Phân Lập B. Thuringiensis -
Giá Trị Lc50, Lt50 Của Các Chủng Vi Khuẩn B. Thuringiensis Var. Kurstaki Đối Với Sâu Tơ, Sâu Khoang, Sâu Xanh Da Láng Trong Điều Kiện Phòng Thí Nghiệm -
Ảnh Hưởng Của Nhiệt Độ Đến Sinh Khối Của Vi Khuẩn -
Mật Độ Vi Khuẩn (Log Cfu/ml) Trong Chế Phẩm Vbt Qua Các Thời Gian Bảo Quản Ở Các Nhiệt Độ Khác Nhau. -
Nghiên cứu sự đa dạng và độc tính của vi khuẩn Bacillus thuringiensis var. kurstaki trên sâu ăn lá hại rau ở Việt Nam - 17
Xem toàn bộ 262 trang tài liệu này.
Trong cùng 1 cột, các giá trị có chữ cái theo sau giống nhau thì sự khác biệt không
có ý nghĩa; ns: không khác biệt; **: khác biệt ở mức rất có ý nghĩa.
0 phút 30 phút 60 phút 90 phút 120 phút
Hình 3.14 Khuẩn lạc của các chủng vi khuẩn hình thành qua các mức thời gian chiếu tia UV ở bước sóng 254 nm. (A) VBt27510; (B) VBt2762.1; (C) VBt2119.1; (D) VBt26310.1
Với bước sóng 365 nm, khi chiếu tia UV trong 120 phút, hai chủng VBt2736.2 và VBt2767.6 (0,0 CFU/mL) không có khả năng chống chịu. Các chủng vi khuẩn còn lại có khả năng chống chịu được tia UV, trong đó, chủng VBt21110.1 (6,23 x 104 CFU/mL), VBt26310.1 (3,1 x 105 CFU/mL), VBt2762.1 (3,8 x 105
CFU/mL) và chủng vi khuẩn VBt2751 (6,2 x 104 CFU/mL) có mật độ cao hơn so với các chủng còn lại (Bảng 3.16).
Bảng 3.16 Mật độ bào tử (CFU/mL) của 12 chủng vi khuẩn B. thuringiensis var.
kurstaki sau khi chiếu UV ở bước sóng 365 nm
Chủng vi
Mật độ bào tử (CFU/mL)
0 phút | 30 phút | 60 phút | 90 phút | 120 phút | |
VBt2119.1 | 2,0 x 108 | 4,6 x 105 a | 3,7 x 105 b | 3,3 x 104 ab | 2,8 x 102 a |
VBt21110.1 | 2,0 x 108 | 2,0 x 107 b | 5,6 x 106 cd | 2,0 x 105 bc | 6,2 x 104 c |
VBt26310.1 | 2,0 x 108 | 1,0 x 108 c | 1,5 x 107 d | 3,2 x 106 c | 3,1 x 105 c |
VBt26311.1 | 2,0 x 108 | 4,9 x 105 a | 1,3 x 105 a | 2,2 x 104 ab | 2,8 x 102 a |
VBt26317.3 | 2,0 x 108 | 1,0 x 107 b | 1,2 x 106 bc | 2,2 x 105 bc | 4,1 x 103 b |
VBt2813 | 2,0 x108 | 3,6 x 107 bc | 5,1 x 106 cd | 1,6 x 106 b | 2,7 x 104 bc |
VBt2735.1 | 2,0 x108 | 3,3 x 107 bc | 1,9 x 107 d | 1,7 x 106 c | 3,4 x 104 bc |
VBt2736.2 | 2,0 x 108 | 1,9 x 107 a | 4,4 x 105 a | 3,9 x 103a | 0,0 a |
VBt2751 | 2,0 x 108 | 1,6 x 107 b | 5,6 x 106 cd | 2,0 x 105 bc | 6,2 x 104 bc |
VBt27510 | 2,0 x 108 | 8,4 x 106 b | 1,3 x 106 bc | 2,2 x 105 bc | 8,7 x 103 b |
VBt2762.1 | 2,0 x 108 | 3,9 x 107 bc | 2,9 x 107 b | 4,0 x 106 c | 3,8 x 105 c |
VBt2767.6 | 2,0 x108 | 2,5 x 107 bc | 5,6 x 106 cd | 5,9 x 103 ab | 0,0 a |
Mức ý nghĩa | ns | ** | ** | ** | ** |
CV % | - | 12,3 | 15,0 | 16,9 | 5,2 |
Trong cùng 1 cột, các giá trị có chữ cái theo sau giống nhau thì sự khác biệt không
có ý nghĩa; ns: không khác biệt; **: khác biệt ở mức rất có ý nghĩa.
Kết quả thực nghiệm ghi nhận, ba chủng VBt21110.1, VBt26310.1, VBt2751 có khả năng chống chịu tia UV cao và được chọn để đánh giá hiệu quả gây chết sâu tơ, sâu khoang và sâu xanh da láng.
0 phút
30 phút
60 phút
90 phút
120 phút
Hình 3.15 Khuẩn lạc của các chủng vi khuẩn hình thành qua các mức thời gian chiếu tia UV ở bước sóng 365 nm. (A) VBt2736.2; (B) VBt2767.6; (C) VBt2119.1; (D) VBt26310.1
3.6.2 Hiệu quả gây chết sâu của các chủng vi khuẩn B. thuringiensis var.
kusrtaki có khả năng chống chịu tia UV trong điều kiện phòng thí nghiệm
Qua kết quả ở bảng 3.17, khả năng gây chết sâu non, sâu tơ của các chủng vi khuẩn B. thuringiensis var. kurstaki đã được chiếu tia UV thấp hơn so với cùng chủng vi khuẩn không bị chiếu tia UV. Cụ thể, ở thời điểm 1 NSXL hiệu quả gây chết sâu tơ của chủng VBt21110.1ȍUV chỉ đạt 15,0% so với chủng VBt21110.1 đạt 30% và các chủng còn lại cǜng cho kết quả tương tự. Đến 7 NSXL, hiệu quả gây chết sâu tơ đạt cao nhất 65,0% (VBt21110.1ȍUV) và thấp nhất là chủng
VBt26310.1ȍUV (đạt 45,0%), trong khi đó, các chủng vi khuẩn không chiếu tia UV lần lượt là 80,5% (VBt21110.1) và 70% (VBt26310.1).
Bảng 3.17. Diễn biến mật độ sâu tơ sống sót sau xử lý vi khuẩn
Mật độ sâu tơ (con/công thức)
TKXL | 1 NSXL | 2 NSXL | 3 NSXL | 5 NSXL | 7 NSXL | |
VBt21110.1ȍUV | 10,0 | 8,8 bcd | 7,3 b | 6,8 ab | 6,3 b | 4,8 b |
VBt26310.1ȍUV | 10,0 | 9,5 cd | 8,3 c | 7,5 c | 6,5 b | 5,3 c |
VBt2751ȍUV | 10,0 | 10,0 d | 8,5 c | 7,8 d | 7,0 d | 6,3 c |
VBt21110.1 | 10,0 | 6,5 a | 5,3 a | 4,5 a | 3,5 a | 2,3 a |
VBt26310.1 | 10,0 | 8,0 ab | 7,3 b | 6,5 b | 5,0 b | 3,3 b |
VBt2751 | 10,0 | 7,3 abc | 6,3 b | 5,3 b | 4,0 b | 3,0 a |
ĐC | 10,0 | 10,0 d | 10,0 d | 10,0 e | 10,0 e | 10,0 d |
Mức ý nghĩa | ns | ** | ** | ** | ** | ** |
CV (%) | 5,4 | 4,7 | 8,0 | 7,8 | 8,2 |
Chủng vi khuẩn
Trong cùng 1 cột, các giá trị có chữ cái đi kèm giống nhau thì sự khác biệt không có ý nghĩa; ns: không có sự khác biệt; **: khác biệt ở mức rất có ý nghĩa; TKXL: trước khi xử lý, NSXL: Ngày sau xử lý; Mật độ vi khuẩn 108 CFU/mL, Đối chứng phun nước cất liều lượng 100 mL; VBt21110.1ΔUV, VBt26310.1ΔUV, VBt2751ΔUV là những chủng chống chịu tia UV; VBt21110.1, VBt26310.1, VBt2751 là những chủng không chiếu tia UV.
Bảng 3.18 Hiệu quả gây chết (%) sâu tơ của các chủng vi khuẩn
Chủng vi khuẩn Hiệu quả gây chết (%) sâu tơ
1 NSXL | 2 NSXL | 3 NSXL | 5 NSXL | 7 NSXL | |
VBt21110.1ȍUV | 15,0 | 40,0 | 52,5 | 60,0 | 65,0 |
VBt26310.1ȍUV | 7,5 | 15,0 | 17,5 | 35,0 | 45,0 |
VBt2751ȍUV | 10,0 | 17,5 | 30,0 | 45,0 | 50,0 |
VBt21110.1 | 30,0 | 50,0 | 62,5 | 72,5 | 80,0 |
VBt26310.1 | 20,0 | 35,0 | 45,0 | 55,0 | 70,0 |
VBt2751 | 22,5 | 32,5 | 47,5 | 62,5 | 77,5 |
90.0
80.0
70.0
60.0
50.0
40.0
30.0
20.0
10.0
0.0
1 NSXL 2 NSXL 3 NSXL 5 NSXL 7 NSXL VBt21110.1 UV VBt26310.1 UV VBt2751 UV VBt21110.1 VBt26310.1 VBt2751
Hình 3.16 Hiệu quả gây chết (%) sâu khoang của các chủng vi khuẩn B.
thuringiensis var. kurstaki đã được chiếu tia UV
90.0
80.0
70.0
60.0
50.0
40.0
30.0
20.0
10.0
0.0
1 NSXL 2 NSXL 3 NSXL 5 NSXL 7 NSXL
VBt21110.1 UV VBt26310.1 UV VBt2751 UV VBt21110.1 VBt26310.1 VBt2751
Hình 3.17 Hiệu quả gây chết (%) sâu xanh da láng của các chủng vi khuẩn B. thuringiensis var. kurstaki đã được chiếu tia UV
Kết quả thử nghiệm ở hình 3.16 và 3.17, cho thấy hiệu quả gây chết sâu khoang và sâu xanh da láng của các chủng vi khuẩn đã được chiếu tia UV ở 7
NSXL khá thấp, chủng vi khuẩn VBt21110.1ȍUV đạt 57,5% đối với sâu khoang, 52,5% đối với sâu xanh da láng, và 65,0% đối với sâu tơ; trong khi chủng VBt2751ȍUV chỉ đạt lần lượt là 32,5% và 37,5% đối với sâu khoang và sâu xanh da láng.
Như vậy, khả năng phát triển và độc tính của vi khuẩn giảm đáng kể, ảnh hưởng đến khả năng diệt sâu sau khi chiếu xạ tia UV ở bước sóng từ 250 đến 380 nm (Setlow, 1994; Mark và ctv, 2000). Trong nghiên cứu này, tia UV ảnh hưởng rõ rệt đến sức sống của vi khuẩn, khả năng hình thành bào tử và tinh thể các chủng vi khuẩn, khiến chúng đều bị ảnh hưởng nghiêm trọng. Khi chiếu tia UV ở bước sóng 254 nm, số khuẩn lạc hình thành và mật độ bào tử vi khuẩn ít hơn so với chiếu tia UV ở bước sóng 365 nm.
3.7 Tối ưu điều kiện lên men của vi khuẩn B. thuringiensis var. kurstaki
3.7.1 Ảnh hưởng của môi trường dinh dưỡng đến sinh khối vi khuẩn
Ba chủng vi khuẩn VBt21110.1 (mẫu phân lập từ tỉnh Vĩnh Phúc), VBt26310.1 (Lâm Đồng), VBt2751 (Bến Tre) mang gen cry1, cry2, cry9 và là những gen độc gây chết cho bộ cánh vảy được thử nghiệm nhân sinh khối với bốn loại môi trường ở điều kiện nhiệt độ 300C, pH 7 và 1% dịch tăng sinh (105 CFU/mL).

Hình 3.18 Mật độ vi khuẩn Bacillus thuringiensisở các môi trường dinh dưỡng
Sau 48 giờ, mật độ trung bình của ba chủng vi khuẩn trong môi trường (MT) 3 (dịch chiết nấm men và các khoáng) đạt cao nhất (8,56÷8,82 log10 CFU/mL, ở môi trường 2 đạt thấp nhất (7,55÷7,71 log10 CFU/mL) (Hình 3.18).
3.7.1.1 Ảnh hưởng của thời gian lên men đến sinh khối vi khuẩn
Mật độ của 3 chủng vi khuẩn đạt cao nhất sau 48 giờ nuôi cấy và khác biệt có ý nghĩa đối với các mốc thời gian còn lại (p<0,05), trong đó, chủng VBt21110.1 đạt 8,83 log CFU/mL, VBt26310.1 đạt 8,76 log CFU/mL và VBt2751 đạt 8,72 log CFU/mL (Hình 3.19).

Hình 3.19 Mật độ vi khuẩn Bacillus thuringiensis ở các thời gian lên men
Theo Nguyễn Thị Hoài Hà và Ngô Giang Liên (2003), thời gian sinh trưởng của vi khuẩn B. thuringiensis rất ngắn, thời gian càng dài thì sinh khối vi khuẩn nhân lên càng giảm. Kết quả thí nghiệm cho thấy, các chủng vi khuẩn đều sinh trưởng, phát triển tốt và đạt mật độ tối ưu ở thời gian 48 giờ, sau 48 giờ sinh khối bắt đầu giảm nhanh. Thời gian tối ưu nhân sinh khối các chủng B. thuringiensis là 48 giờ, và được sử dụng cho các thí nghiệm tiếp theo.
3.7.1.2 Ảnh hưởng của pH môi trường đến sinh khối vi khuẩn
Mật độ vi khuẩn chủng VBt21110.1 đạt giá trị cao nhất là 8,71 log CFU/mL ở pH 8, nhưng không khác biệt ở pH 7 và 7,5. Mật độ vi khuẩn chủng VBt26310.1 ở






